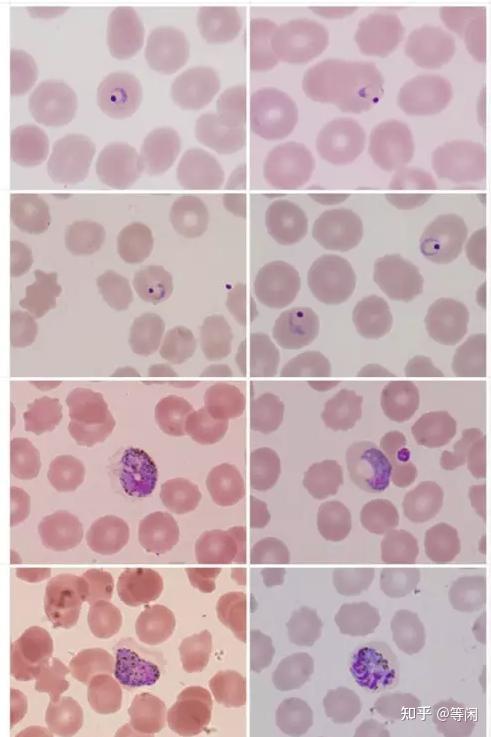
武松和青蒿素浅谈疟疾

疟虫

科学美国人60秒:一些疟蚊可能更喜欢牛而不是人类
图片尺寸700x468
4岁女孩死于疟疾 意大利或发现热带盛行的蚊虫传染病
图片尺寸950x534
疟蚊.
图片尺寸1200x881
疟疾能抗癌为时尚早吧
图片尺寸1000x598
疟原虫abc转运体表达,转运体名词解释,abc转运系统
图片尺寸1362x752
婺源县疾控中心不忘初心,守护健康-2020霍乱,疟疾检测技术培训
图片尺寸600x800
疟疾虫
图片尺寸500x507
疟原虫
图片尺寸1080x810
中国连续3年无本土疟疾病例报告,2019年境外输入达2673例死亡19例
图片尺寸840x480
疟疾也叫"打摆子"
图片尺寸2500x1875
全国疟疾日这场古老的瘟疫一点都不逊色于新冠肺炎
图片尺寸400x300
得了疟疾会出现哪些症状?
图片尺寸382x300
武松和青蒿素浅谈疟疾
图片尺寸491x737
中国消除疟疾获世卫组织认证防止输入性病例成新挑战
图片尺寸700x398
疟蚊.
图片尺寸1100x1100
口服抗原虫药物
图片尺寸800x533
揭示了难以捉摸的人类疟疾物种的基因组秘密
图片尺寸500x337
疟疾候选药物可能会减少寄生虫的传播
图片尺寸500x330
疟蚊,自然,水平画幅,无人,疟疾
图片尺寸1121x1100
世界疟疾日揭秘我们为啥叫打摆子
图片尺寸585x492